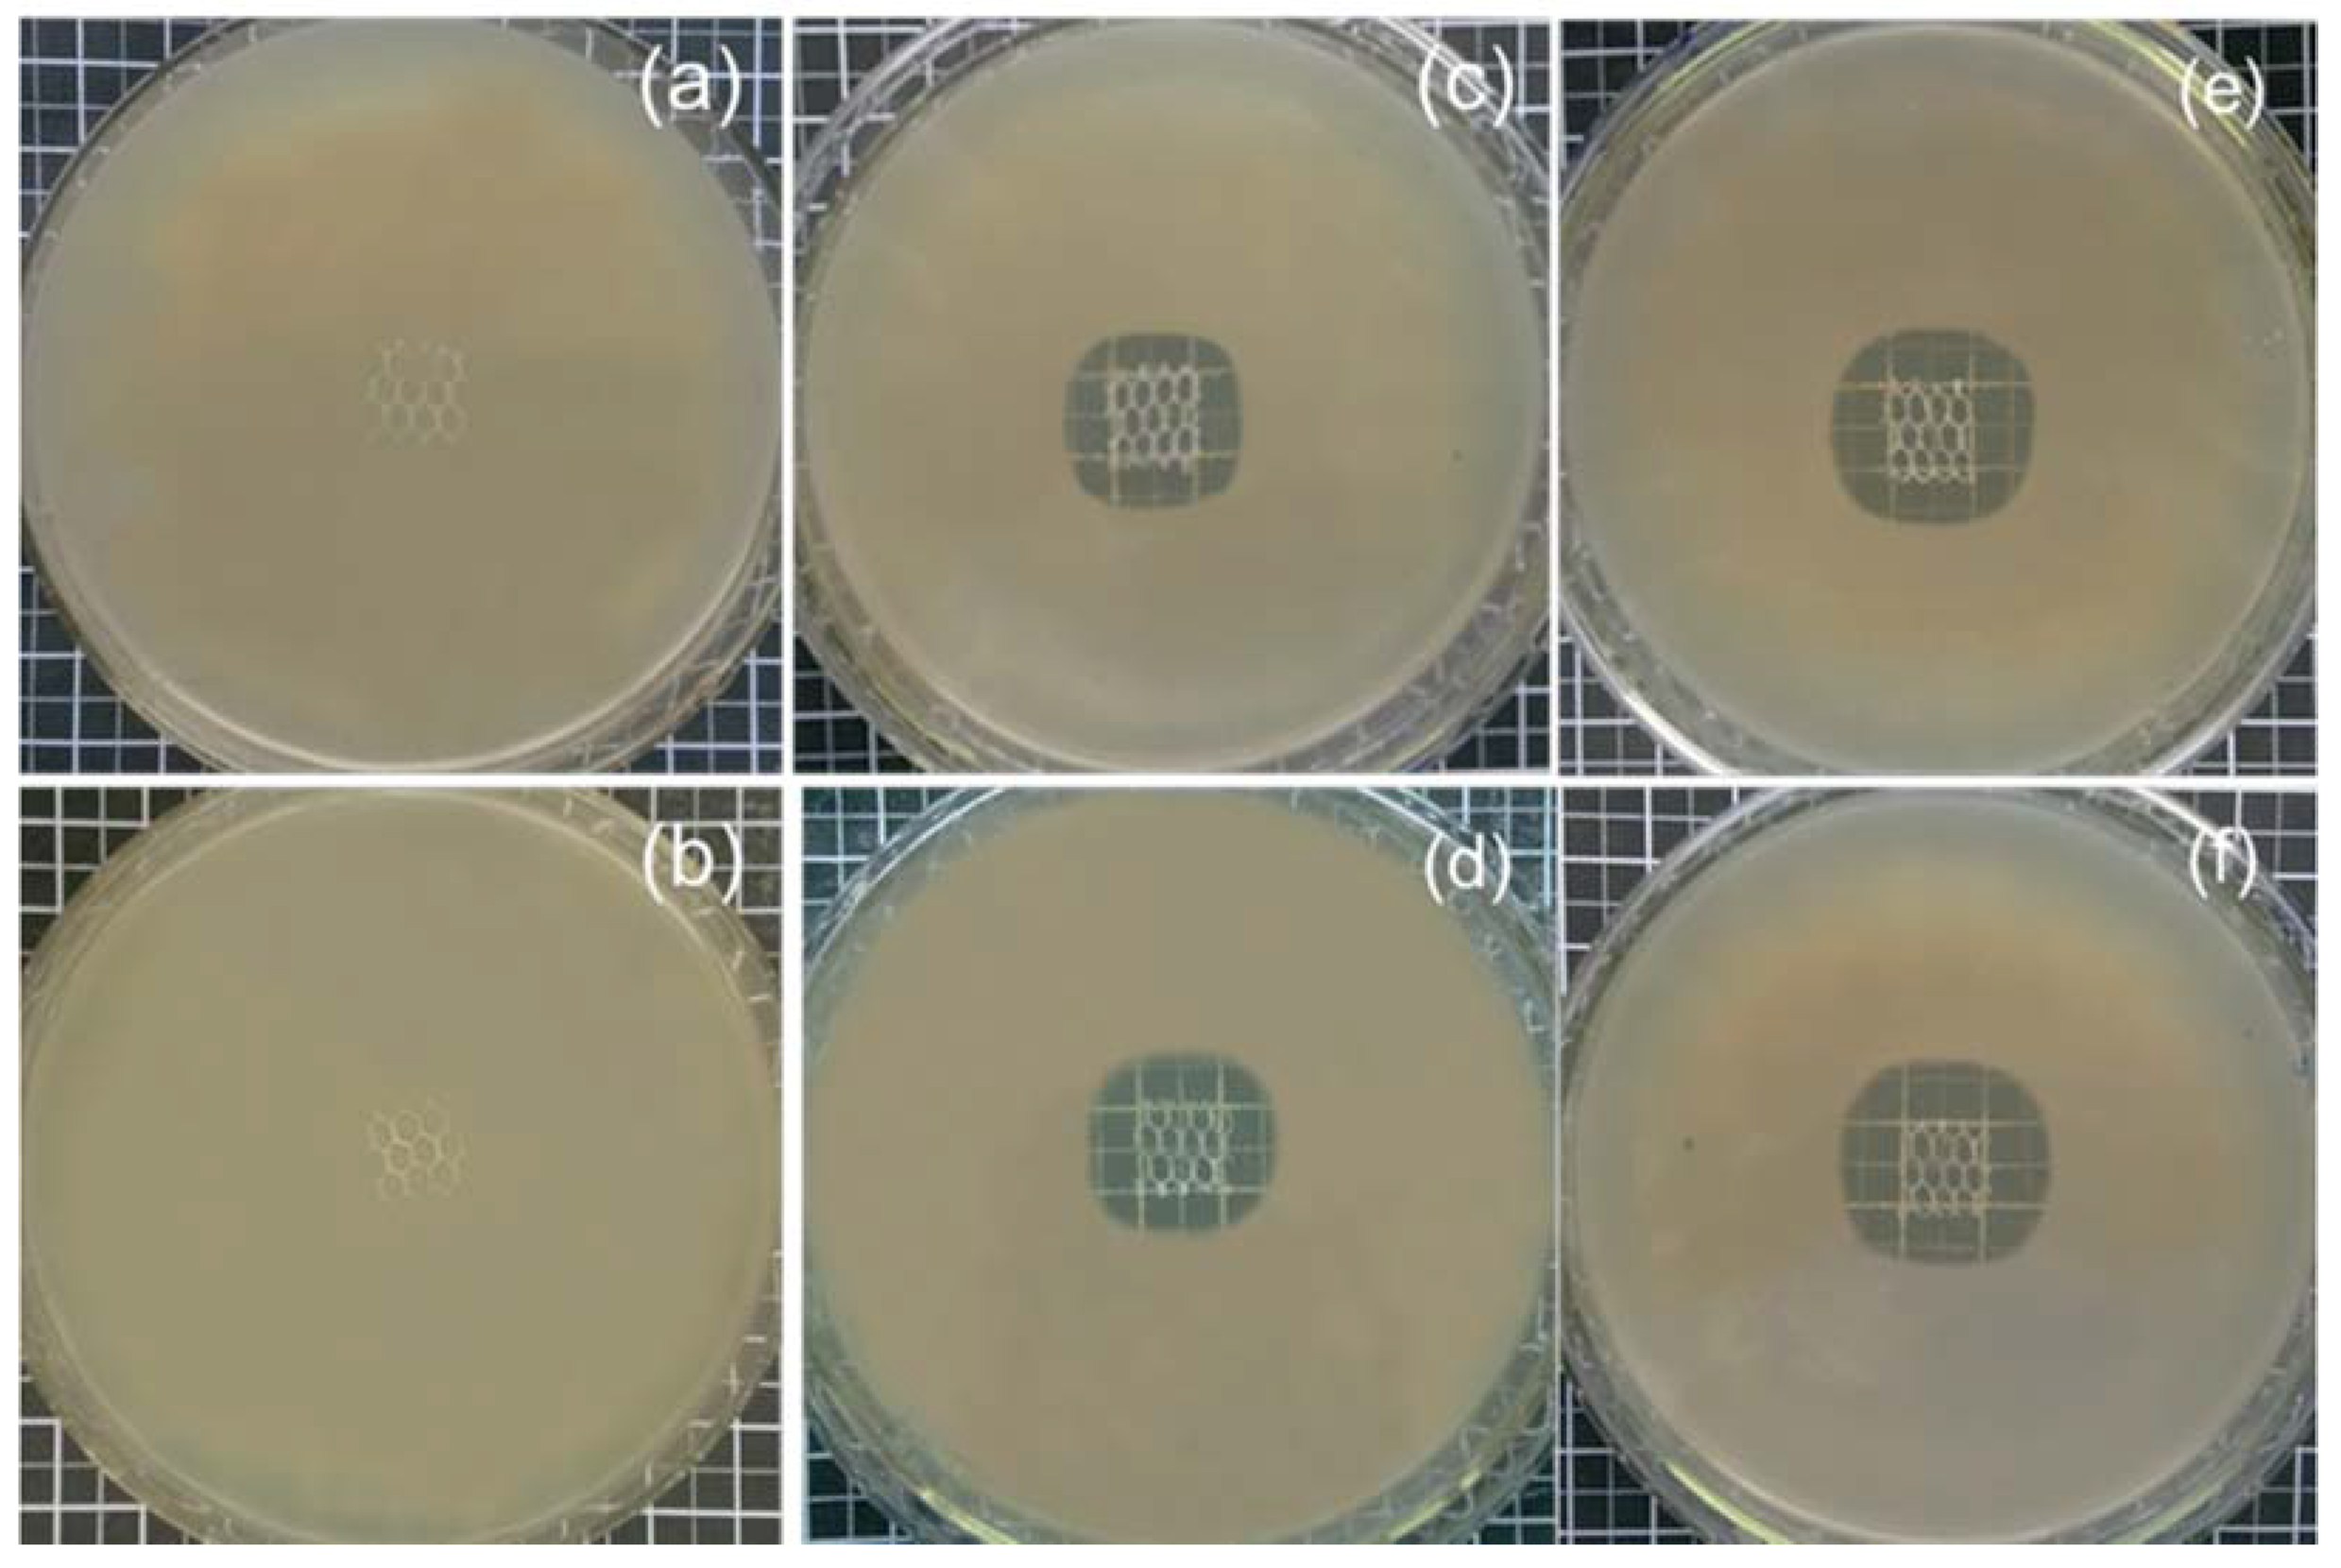
Polymers 10 00493 g007 550

Controlled Levofloxacin Release and Antibacterial Properties of β-Cyclodextrins-Grafted Polypropylene Mesh Devices for Hernia Repair
Abstract
:1. Introduction
2. Materials and Methods
2.1. Materials
2.2. Methods
2.2.1. Surface Functionalization of PP Meshes with Oxygen Plasma
2.2.2. Grafting HDI-CD onto PP Meshes in Two Steps
2.2.3. Kinetics of Loading and Release of Levofloxacin HCL
3. Characterization
3.1. SEM and EDX
3.2. FTIR
3.3. Antibacterial Activity Assessment
4. Results and Discussion
4.1. Cyclodextrin Grafting and Levofloxacin HCL Loading
4.2. Surface Morphology of PP Meshes
4.3. Characterization of HDI, CD Grafting, and Levofloxacin-Loaded Modified PP Mesh
4.4. Antibacterial Activity of Modified PP Meshes
4.5. Release Kinetics of Levofloxacin HCL
5. Conclusions
Author Contributions
Funding
Acknowledgments
Conflicts of Interest
References
- Miao, L.; Wang, F.; Wang, L.; Zou, T.; Brochu, G.; Guidoin, R. Physical characteristics of medical textile prostheses designed for hernia repair: A comprehensive analysis of select commercial devices. Materials 2015, 8, 8148–8168. [Google Scholar] [CrossRef] [PubMed]
- Park, A.E.; Roth, J.S.; Kavic, S.M. Abdominal wall hernia. Curr. Probl. Surg. 2006, 43, 326–375. [Google Scholar] [CrossRef] [PubMed]
- Brown, C.N.; Finch, J.G. Which mesh for hernia repair. Ann. R. Coll. Surg. Engl. 2010, 92, 272–278. [Google Scholar] [CrossRef] [PubMed]
- Bilsel, Y.; Abci, I. The search for ideal hernia repair; mesh materials and types. Int. J. Surg. 2012, 10, 317–321. [Google Scholar] [CrossRef] [PubMed]
- Hazebroek, E.J.; Ng, A.; Yong, D.H.; Berry, H.; Leibman, S.; Smith, G.S. Evaluation of lightweight titanium-coated polypropylene mesh (timesh) for laparoscopic repair of large hiatal hernias. Surg. Endosc. 2008, 22, 2428–2432. [Google Scholar] [CrossRef] [PubMed]
- Klinge, U.; Klosterhalfen, B.; Birkenhauer, V.; Junge, K.; Conze, J.; Schumpelick, V. Impact of polymer pore size on the interface scar formation in a rat model. J. Surg. Res. 2002, 103, 208–214. [Google Scholar] [CrossRef] [PubMed]
- Gil, D.; Rex, J.; Cobb, W.; Reukov, V.; Vertegel, A. Anti-inflammatory coatings of hernia repair meshes: A pilot study. J. Biomed. Mater. Res. 2018, 106, 589–597. [Google Scholar] [CrossRef] [PubMed]
- Sanbhal, N.; Miao, L.; Xu, R.; Khatri, A.; Wang, L. Physical structure and mechanical properties of knitted hernia mesh materials: A review. J. Ind. Text. 2017, 0, 1–28. [Google Scholar] [CrossRef]
- Guillaume, O.; Perez-Tanoira, R.; Fortelny, R.; Redl, H.; Moriarty, T.F.; Richards, R.G.; Eglin, D.; Petter Puchner, A. Infections associated with mesh repairs of abdominal wall hernias: Are antimicrobial biomaterials the longed-for solution? Biomaterials 2018, 167, 15–31. [Google Scholar] [CrossRef] [PubMed]
- Kulaga, E.; Ploux, L.; Balan, L.; Schrodj, G.; Roucoules, V. Mechanically responsive antibacterial plasma polymer coatings for textile biomaterials. Plasma Process. Polym. 2014, 11, 63–79. [Google Scholar] [CrossRef]
- Knetsch, M.L.W.; Koole, L.H. New strategies in the development of antimicrobial coatings: The example of increasing usage of silver and silver nanoparticles. Polymers 2011, 3, 340–366. [Google Scholar] [CrossRef]
- Nisticò, R.; Faga, M.G.; Gautier, G.; Magnacca, G.; D’Angelo, D.; Ciancio, E.; Piacenza, G.; Lamberti, R.; Martorana, S. Physico-chemical characterization of functionalized polypropylenic fibers for prosthetic applications. Appl. Surf. Sci. 2012, 258, 7889–7896. [Google Scholar] [CrossRef]
- Perez-Kohler, B.; Fernandez-Gutierrez, M.; Pascual, G.; Garcia-Moreno, F.; San Roman, J.; Bellon, J.M. In vitro assessment of an antibacterial quaternary ammonium-based polymer loaded with chlorhexidine for the coating of polypropylene prosthetic meshes. Hernia 2016, 20, 869–878. [Google Scholar] [CrossRef] [PubMed]
- Labay, C.; Canal, J.M.; Modic, M.; Cvelbar, U.; Quiles, M.; Armengol, M.; Arbos, M.A. Antibiotic-loaded polypropylene surgical meshes with suitable biological behaviour by plasma functionalization and polymerization. Biomaterials 2015, 71, 132–144. [Google Scholar] [CrossRef] [PubMed]
- Guillaume, O.; Garric, X.; Lavigne, J.P.; Van Den Berghe, H.; Coudane, J. Multilayer, degradable coating as a carrier for the sustained release of antibiotics: Preparation and antimicrobial efficacy in vitro. J. Control. Release 2012, 162, 492–501. [Google Scholar] [CrossRef] [PubMed]
- Zhang, Z.; Tang, J.; Wang, H.; Xia, Q.; Xu, S.; Han, C.C. Controlled antibiotics release system through simple blended electrospun fibers for sustained antibacterial effects. ACS Appl. Mater. Interfaces 2015, 7, 26400–26404. [Google Scholar] [CrossRef] [PubMed]
- Vermet, G.; Degoutin, S.; Chai, F.; Maton, M.; Flores, C.; Neut, C.; Danjou, P.E.; Martel, B.; Blanchemain, N. Cyclodextrin modified plla parietal reinforcement implant with prolonged antibacterial activity. Acta Biomater. 2017, 53, 222–232. [Google Scholar] [CrossRef] [PubMed]
- Cheirsilp, B.; Rakmai, J. Inclusion complex formation of cyclodextrin with its guest and their applications. Biol. Eng. Med. 2016, 2, 1–6. [Google Scholar] [CrossRef]
- Yee, E.M.; Hook, J.M.; Bhadbhade, M.M.; Vittorio, O.; Kuchel, R.P.; Brandl, M.B.; Tilley, R.D.; Black, D.S.; Kumar, N. Preparation, characterization and in vitro biological evaluation of (1:2) phenoxodiol-beta-cyclodextrin complex. Carbohydr. Polym. 2017, 165, 444–454. [Google Scholar] [CrossRef] [PubMed]
- Choi, J.M.; Park, K.; Lee, B.; Jeong, D.; Dindulkar, S.D.; Choi, Y.; Cho, E.; Park, S.; Yu, J.H.; Jung, S. Solubility and bioavailability enhancement of ciprofloxacin by induced oval-shaped mono-6-deoxy-6-aminoethylamino-beta-cyclodextrin. Carbohydr. Polym. 2017, 163, 118–128. [Google Scholar] [CrossRef] [PubMed]
- Szente, L.; Szeman, J.; Sohajda, T. Analytical characterization of cyclodextrins: History, official methods and recommended new techniques. J. Pharm. Biomed. Anal. 2016, 130, 347–365. [Google Scholar] [CrossRef] [PubMed]
- Thatiparti, T.R.; Shoffstall, A.J.; von Recum, H.A. Cyclodextrin-based device coatings for affinity-based release of antibiotics. Biomaterials 2010, 31, 2335–2347. [Google Scholar] [CrossRef] [PubMed]
- Thatiparti, T.R.; von Recum, H.A. Cyclodextrin complexation for affinity-based antibiotic delivery. Macromol. Biosci. 2010, 10, 82–90. [Google Scholar] [CrossRef] [PubMed]
- Jelić, R.; Tomović, M.; Stojanović, S.; Joksović, L.; Jakovljević, I.; Djurdjević, P. Study of inclusion complex of β-Cyclodextrin and levofloxacin and its effect on the solution equilibria between gadolinium(iii) ion and levofloxacin. Monatshefte Chem. Chem. Mon. 2015, 146, 1621–1630. [Google Scholar] [CrossRef]
- Ren, Q.; Zhu, X. Methyl-beta-cyclodextrin /cetyltrimethyl ammonium bromide synergistic sensitized fluorescence method for the determination of levofloxacin. J. Fluoresc. 2016, 26, 671–677. [Google Scholar] [CrossRef] [PubMed]
- Zhang, Z.; Zhang, T.; Li, J.; Ji, Z.; Zhou, H.; Zhou, X.; Gu, N. Preparation of poly(l-lactic acid)-modified polypropylene mesh and its antiadhesion in experimental abdominal wall defect repair. J. Biomed. Mater. Res. 2014, 102, 12–21. [Google Scholar] [CrossRef] [PubMed]
- Fauland, G.; Constantin, F.; Gaffar, H.; Bechtold, T. Production scale plasma modification of polypropylene baselayer for improved water management properties. J. Appl. Polym. Sci. 2015, 132, 1–8. [Google Scholar] [CrossRef]
- Rosen, M.J. Polyester-based mesh for ventral hernia repair: Is it safe? Am. J. Surg. 2009, 197, 353–359. [Google Scholar] [CrossRef] [PubMed]
- Sanbhal, N.; Mao, Y.; Sun, G.; Li, Y.; Peerzada, M.; Wang, L. Preparation and characterization of antibacterial polypropylene meshes with covalently incorporated β-Cyclodextrins and captured antimicrobial agent for hernia repair. Polymers 2018, 10, 58. [Google Scholar] [CrossRef]
- Nava-Ortiz, C.A.; Alvarez-Lorenzo, C.; Bucio, E.; Concheiro, A.; Burillo, G. Cyclodextrin-functionalized polyethylene and polypropylene as biocompatible materials for diclofenac delivery. Int. J. Pharm. 2009, 382, 183–191. [Google Scholar] [CrossRef] [PubMed]
- Sarau, G.; Bochmann, A.; Lewandowska, R.; Christianse, S. From Micro- to Macro-Raman Spectroscopy: Solar Silicon for a case Study; InTech: Lodz, Poland, 2012. [Google Scholar]
- Gawish, S.M.; Matthews, S.R.; Wafa, D.M.; Breidt, F.; Bourham, M.A. Atmospheric plasma-aided biocidal finishes for nonwoven polypropylene fabrics. I. Synthesis and characterization. J. Appl. Polym. Sci. 2007, 103, 1900–1910. [Google Scholar] [CrossRef]
- Muzio, G.; Miola, M.; Perero, S.; Oraldi, M.; Maggiora, M.; Ferraris, S.; Vernè, E.; Festa, V.; Festa, F.; Canuto, R.A. Polypropylene prostheses coated with silver nanoclusters/silica coating obtained by sputtering: Biocompatibility and antibacterial properties. Surf. Coat. Technol. 2017, 319, 326–334. [Google Scholar] [CrossRef]
- Majumdar, A.; Butola, B.S.; Thakur, S. Development and performance optimization of knitted antibacterial materials using polyester-silver nanocomposite fibres. Mater. Sci. Eng. 2015, 54, 26–31. [Google Scholar] [CrossRef] [PubMed]
- Sanbhal, N.; Mao, Y.; Sun, G.; Xu, R.F.; Zhang, Q.; Wang, L. Surface modification of polypropylene mesh devices with cyclodextrin via cold plasma for hernia repair: Characterization and antibacterial properties. Appl. Surf. Sci. 2018, 439, 749–759. [Google Scholar] [CrossRef]
- Avetta, P.; Nisticò, R.; Faga, M.G.; D'Angelo, D.; Boot, E.A.; Lamberti, R.; Martorana, S.; Calza, P.; Fabbri, D.; Magnacca, G. Hernia-repair prosthetic devices functionalised with chitosan and ciprofloxacin coating: Controlled release and antibacterial activity. J. Mater. Chem. B 2014, 2, 5287–5294. [Google Scholar] [CrossRef]

© 2018 by the authors. Licensee MDPI, Basel, Switzerland. This article is an open access article distributed under the terms and conditions of the Creative Commons Attribution (CC BY) license (http://creativecommons.org/licenses/by/4.0/).
Share and Cite
Sanbhal, N.; Saitaer, X.; Li, Y.; Mao, Y.; Zou, T.; Sun, G.; Wang, L. Controlled Levofloxacin Release and Antibacterial Properties of β-Cyclodextrins-Grafted Polypropylene Mesh Devices for Hernia Repair. Polymers 2018, 10, 493. https://doi.org/10.3390/polym10050493
Sanbhal N, Saitaer X, Li Y, Mao Y, Zou T, Sun G, Wang L. Controlled Levofloxacin Release and Antibacterial Properties of β-Cyclodextrins-Grafted Polypropylene Mesh Devices for Hernia Repair. Polymers. 2018; 10(5):493. https://doi.org/10.3390/polym10050493
Chicago/Turabian StyleSanbhal, Noor, Xiakeer Saitaer, Yan Li, Ying Mao, Ting Zou, Gang Sun, and Lu Wang. 2018. "Controlled Levofloxacin Release and Antibacterial Properties of β-Cyclodextrins-Grafted Polypropylene Mesh Devices for Hernia Repair" Polymers 10, no. 5: 493. https://doi.org/10.3390/polym10050493
APA StyleSanbhal, N., Saitaer, X., Li, Y., Mao, Y., Zou, T., Sun, G., & Wang, L. (2018). Controlled Levofloxacin Release and Antibacterial Properties of β-Cyclodextrins-Grafted Polypropylene Mesh Devices for Hernia Repair. Polymers, 10(5), 493. https://doi.org/10.3390/polym10050493




